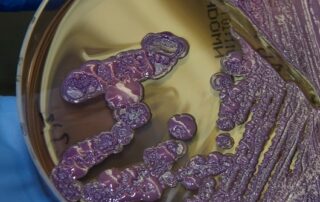
scientists-make-promising-breakthrough-against-superbug-that-attacks-australian-icu-patients

‘Returned under the cover of darkness’: Galah painting and nutcracker statue found after alleged thefts
David Warner's cap might have captured the nation, but it's [...]
Disability service provider ‘deeply saddened’ after client died while waiting for an ambulance
A disability provider says it is "deeply saddened" by the [...]
River Murray residents still in limbo a year after flooding
Read our editorial guiding principles
Jesse has run an online community forum for 12 years but threats and abuse have taken their toll
Jesse Norris could have never anticipated the personal toll of [...]
James accepted a free offer to demolish his house after flooding — but found out he was on ‘undocumented’ land
James Bailey is living in a caravan on his riverfront [...]
Scientists make promising breakthrough against superbug that attacks Australian ICU patients
Scientists are hopeful that they have discovered a new class [...]